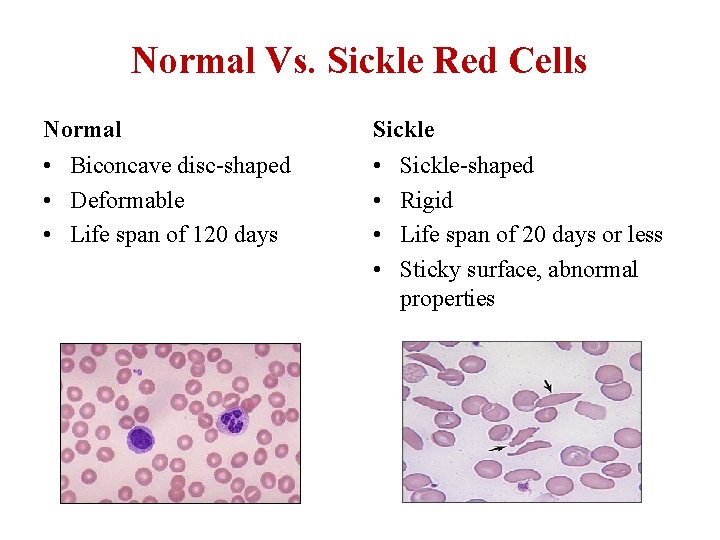
Normal Vs. Sickle Red Cells Normal Sickle • Biconcave disc-shaped • Deformable • Life Normal Vs. Sickle Red Cells Normal Sickle • Biconcave disc-shaped • Deformable • Life

Sickle Cell Disease Core Concepts for the Emergency

- Slides: 18
Sickle Cell Disease: Core Concepts for the Emergency Physician and Nurse Epidemiology, Genetics, Pathophysiology Paula Tanabe, Ph. D, RN, FAEN, FAAN Associate Professor Duke University, Schools of Nursing and Medicine
Objectives • Identify the genotype associated with the most severe form of sickle cell disease (SCD) • Identify the median lifespan for individuals with SCD
Pretest- Question 1 Which genotype is associated with the most severe symptoms? a. SS b. SC c. SB 0 d. SB+
Pretest- Question 2 What is the median lifespan for most individuals with SCD? a. b. c. d. 20’s 30’s 40’s 50’s
Epidemiology of SCD • SCD is a genetic disease affecting 70, 000 – 100, 000 Americans, primarily of African descent 1 – Most common genetic disease among blacks – SCD occurs in 1 of every 500 black births • 1: 1, 100 Hispanics (eastern states) • 1: 32, 000 Hispanics (western states) • SCD occurs in many other ethnic groups, including Northern Europeans and those that live in the Middle Eastern Countries • 1: 12 African-Americans are carriers (trait) for the disorder
SCD Common Genotypes Genotype Approximate % of US Patients • Sickle cell anemia (SS, most 65 % severe form) • Sickle/Hb C disease (SC, lesser 25 % severity, but can still have pain episodes, and life-threatening complications) • Sickle/Beta plus thalassemia 8% + (Sβ thalassemia, similar to SC) • Sickle/Beta zero thalassemia 2% (Sβ° thalassemia, similar to SS)
Comparison of Life Expectancy US Population vs. Sickle Cell Disease
Changes in Life Expectancy • • National Center for Health Statistics 3 Compared 1999 -2007 with 1979 -1998 Largest declines in ages 0 -4 Smaller but significant declines up to age 19 – Due to prophylactic treatment with penicillin and vaccinations – Transcranial doppler screening identifies children at risk of stroke; placed on chronic transfusion therapy to prevent stroke • No differences in the 20 -24 age group • Increase in death rate ages: 45 -54, 55 -65, and 65 -75
What is the pathophysiology?
Normal Vs. Sickle Red Cells Normal Sickle • Biconcave disc-shaped • Deformable • Life span of 120 days • • Sickle-shaped Rigid Life span of 20 days or less Sticky surface, abnormal properties
Prolonged Sickling of RBC’s • After recurrent episodes of sickling – membrane damage occurs – cells not capable of resuming biconcave shape upon reoxygenation • Deformed sickle cells adhere to endothelium & macrophages – induces hemolytic process
Hemolysis and Vaso-occlusion Hemolysis • Anemia in SCD is caused by red cell destruction, or hemolysis Vaso-occlusion: • Complex process initiated by rigid and abnormally shaped sickled RBC’s • Degree of anemia varies widely between patients • Abnormal adhesion occurs to the endothelium • Red cell production by the bone marrow increases dramatically, but is unable to keep pace with the destruction • Activation of WBC’s, RBC’s & the endothelial surface which enhances the VOC process • Results in tissue damage, hypoxia, necrosis, & organ dysfunction
Acute and Chronic Manifestations Acute Manifestations Chronic Manifestations • • • • Bacterial sepsis or meningitis* Recurrent vaso-occlusive pain (dactylitis, musculo-skeletal or abdominal pain) Splenic sequestration* Aplastic crisis* Acute chest syndrome* Stroke* Priapism Hematuria, including papillary necrosis *Potential cause of mortality • • • Anemia Jaundice Splenomegaly Functional asplenia Cardiomegaly and functional murmurs Hyposthenuria and enuresis Proteinemia Cholelithiasis Delayed growth and sexual maturation Restrictive lung disease* Pulmonary hypertension* Avascular necrosis Proliferative retinopathy Leg ulcers Transfusional hemosiderosis*
Clinical Scenario • Cut and paste this link into your browser to view this short video • https: //www. youtube. com/watch? v=Uu 5 VTET lb. ZM&feature=youtu. be
Posttest- Question 1 Which genotype is associated with the most severe symptoms? a. SS b. SC c. SB 0 d. SB+
Posttest- Question 2 What is the median lifespan for most individuals with SCD? a. b. c. d. 20’s 30’s 40’s 50’s
Posttest Answers & Rationale • Question 1 – Answer : a) SS – Rationale: Patients with SS have the most severe form of the disease which is associated with more complications. However, all patients can experience pain and multiple other complications. • Question 2 – Answer: c) 40’s – Rationale: The median lifespan continues to be 48 for females and 42 for males.
References 1. Hassell KL. Population estimates of sickle cell disease in the U. S. Am J Prev Med. 2010; 38(4 S): S 512 -S 521. 2. Platt et al. Mortality in sickle cell disease, life expectancy and risk factors for early death. NEJM 1994. 330: 1639 -44. 3. Hamideh, D. Trends in Mortality Among Patients with SCD in the United States. Is there any change in the past 10 years? 2012. 6 th Annual Sickle Cell Disease Research and Educational Symposium & Annual National SCD Scientific Meeting 4. http: //wonder. cdc. gov/controller/datarequest/D 79